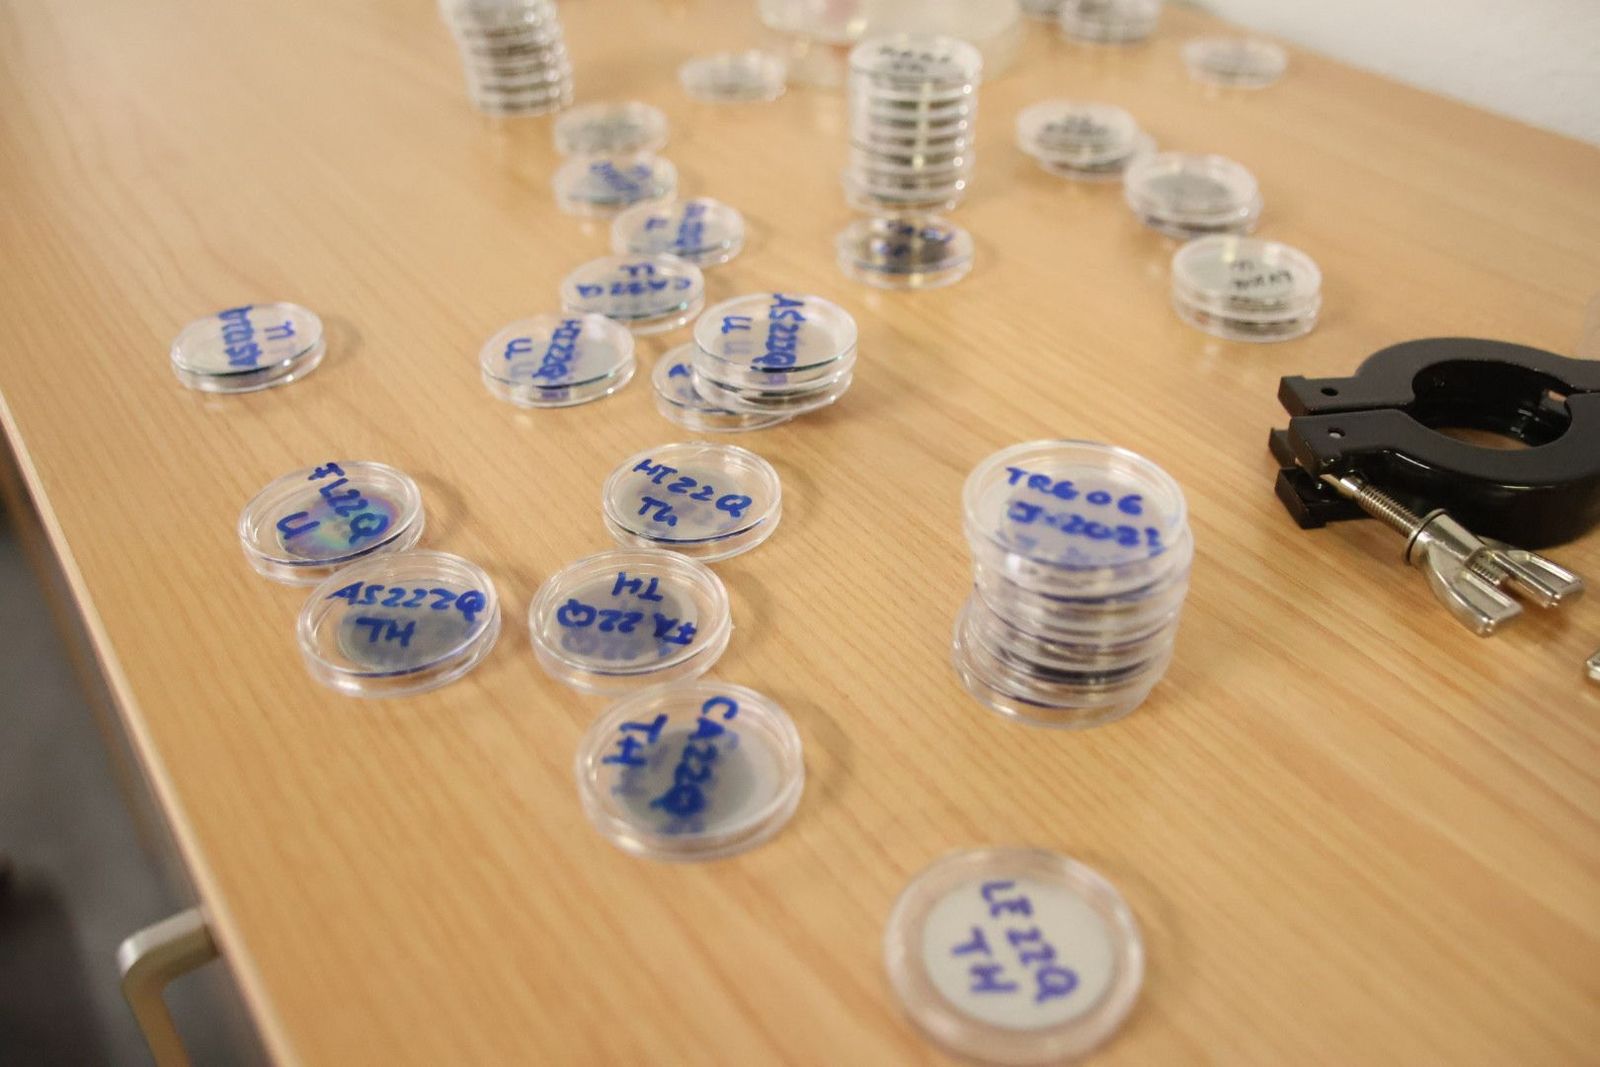
20231013104324-img-3156

GALERÍA | Laboratorio para la Investigación sobre los niveles de radioactividad natural del agua

También te puede interesar
Lo último
